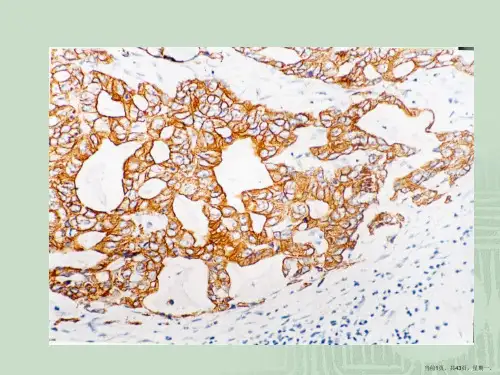

7.免疫组化结果分析和判断
- 格式:ppt
- 大小:553.00 KB
- 文档页数:79



实验结果免疫组化结果解读
免疫组化(immunohistochemistry,IHC)是一种用于检测组织中特定蛋白质表达的技术。
通过对组织切片进行染色,可以观察到特定蛋白在组织中的分布和表达水平。
在解读免疫组化结果时,需要考虑以下几个方面:
1. 样本准备,首先需要确认样本的质量和处理是否符合实验要求。
样本的保存和处理对免疫组化结果至关重要,因为不恰当的处理可能会导致蛋白质的降解或者失活,影响最终的结果。
2. 阳性对照,在解读免疫组化结果时,需要对照阳性对照组织切片,确保实验条件和试剂的有效性。
阳性对照通常是已知含有目标蛋白的组织切片,用于验证实验条件和试剂的有效性。
3. 组织结构,观察组织切片的整体结构和形态,确保实验过程中组织的完整性和准确性。
免疫组化结果需要在正确的组织结构基础上进行解读,以排除可能的伪阳性或伪阴性结果。
4. 染色结果,观察组织切片的染色结果,包括颜色强度、分布和细胞定位。
根据染色结果的强弱和分布情况,可以初步判断目标
蛋白在组织中的表达水平和分布情况。
5. 数据分析,将染色结果进行定量分析,通常使用图像分析系统或者手动计数的方式进行。
通过定量分析可以得到目标蛋白的表达水平,进一步验证免疫组化结果的可靠性和准确性。
6. 结果解读,根据样本准备、阳性对照、组织结构、染色结果和数据分析,对免疫组化结果进行综合解读。
需要考虑目标蛋白在组织中的表达水平和分布情况,结合实验条件和其他实验结果进行综合分析。
综上所述,解读免疫组化结果需要综合考虑多个因素,包括样本准备、阳性对照、组织结构、染色结果、数据分析和综合解读,以确保结果的准确性和可靠性。

免疫组化常见结果及解读免疫组化是一种常用的实验技术,用于检测组织或细胞中特定蛋白质的表达情况。
通过免疫组化可以确定细胞或组织中特定蛋白质的存在、定位和表达水平,从而为疾病的诊断和治疗提供重要的依据。
下面将介绍免疫组化常见结果及其解读。
1. 阳性结果:阳性结果表示目标蛋白质在组织或细胞中存在。
阳性结果可以分为强阳性、中阳性和弱阳性。
强阳性表示目标蛋白质的表达水平很高,中阳性表示表达水平适中,弱阳性表示表达水平较低。
阳性结果的解读需要结合临床病史和其他检查结果来综合判断。
2. 阴性结果:阴性结果表示目标蛋白质在组织或细胞中不存在。
阴性结果可能有多种原因,如目标蛋白质在该组织或细胞中不表达、表达水平很低或实验操作不当等。
阴性结果的解读需要排除其他可能的原因,并结合临床病史和其他检查结果来综合判断。
3. 异常表达:有时免疫组化结果显示目标蛋白质的表达情况与正常组织或细胞有明显差异,称为异常表达。
异常表达可能是疾病的标志,也可能是实验操作不当或其他因素导致的假阳性结果。
解读异常表达结果需要结合临床病史和其他检查结果来综合判断。
4. 亚细胞定位:免疫组化可以确定目标蛋白质在细胞中的亚细胞定位。
常见的亚细胞定位结果包括细胞核、细胞质、细胞膜和细胞器等。
亚细胞定位结果的解读可以提供有关目标蛋白质功能和调控机制的重要信息。
5. 异常分布:有时免疫组化结果显示目标蛋白质在组织中的分布与正常组织有明显差异,称为异常分布。
异常分布可能是疾病的标志,也可能是实验操作不当或其他因素导致的假阳性结果。
解读异常分布结果需要结合临床病史和其他检查结果来综合判断。
6. 异常表达模式:有时免疫组化结果显示目标蛋白质的表达模式与正常组织有明显差异,称为异常表达模式。
异常表达模式可能是疾病的标志,也可能是实验操作不当或其他因素导致的假阳性结果。
解读异常表达模式结果需要结合临床病史和其他检查结果来综合判断。
总之,免疫组化常见结果的解读需要结合临床病史和其他检查结果来综合判断。

免疫组化结果判断标准免疫组化(Immunohistochemistry,IHC)是一种通过使用特定的抗体来检测组织样本中特定蛋白质的方法。
通过对免疫组化结果进行判断和分析,可以为临床医生提供重要的诊断和预后信息。
在免疫组化结果的判断中,常见的标准有阳性标记、定量分析、判定阴性、强度评分等。
免疫组化结果按照阳性标记分为阴性和阳性。
阳性结果表示目标蛋白质的表达存在,而阴性结果表示目标蛋白质的表达不存在。
在判断免疫组化结果时,需要注意结果的可靠性和准确性。
一般来说,阳性结果需要出现明显的染色反应,在组织样本中产生特定的颜色变化,而阴性结果则需要获得几乎无染色反应的结果。
除了阳性标记外,还可以通过定量分析来判断免疫组化结果。
定量分析可以通过使用计算机软件或图像分析系统,对免疫组化结果图像中的染色强度和染色面积进行计算和量化。
通过定量分析,可以量化目标蛋白质的表达水平,并与其他样本进行比较和分析,从而得出更加客观和可靠的结果。
在免疫组化结果的判断中,还有一种常见的标准是判定阴性。
判定阴性是指使用阴性对照和负对照来确定免疫组化染色的结果是否是阴性。
阴性对照是指在免疫组化实验中使用无目标蛋白质的组织样本或细胞,负对照是指在免疫组化实验中使用无抗体的组织样本或细胞。
通过对阴性对照和负对照的染色结果进行比较和分析,可以确定是否存在非特异性染色或假阳性结果。
除了以上几种标准外,免疫组化结果的判断还可以通过强度评分进行。
强度评分是根据染色的强烈程度对结果进行判断和评分的方法。
一般来说,免疫组化结果的强度可以分为负(0)、弱(1+)、中(2+)和强(3+)四个等级。
这种评分方法可以为临床医生提供蛋白质表达的定量信息,并帮助他们作出更加准确和可靠的诊断和预后判断。
总之,免疫组化结果的判断标准包括阳性标记、定量分析、判定阴性和强度评分等。
通过合理地应用这些标准,可以为临床医生提供重要的蛋白质表达信息,从而指导临床诊断和治疗决策。

免疫组化结果判断标准免疫组化结果判断标准指的是在免疫组化检测中,根据染色结果和特定的标准对检测样本进行判断和解读的规则。
免疫组化是一种常用的实验方法,用于检测组织切片或细胞中特定的蛋白质表达情况。
在免疫组化实验中,通常使用标记有特异性抗体的试剂与目标抗原结合,形成颜色沉积或荧光信号。
免疫组化结果根据检测物的染色程度、强度和分布模式来判断。
以下是一些常见的免疫组化结果判断标准:1. 阳性(Positive):表示目标抗原在组织或细胞中存在。
阳性结果通常可以观察到明显的染色和强度,其分布模式可能是全细胞膜、核、细胞质等。
2. 阴性(Negative):表示目标抗原在组织或细胞中不存在。
阴性结果通常观察不到染色或染色非常弱,且不符合阳性的染色模式。
3. 弱阳性(Weak Positive):染色结果显示为弱的阳性信号,通常比阳性样本的染色强度要低。
4. 血管内内皮细胞阳性(Vascular Endothelial Cell Positive):此结果表示目标抗原在血管内皮细胞中存在。
5. 炎症细胞阳性(Inflammatory Cell Positive):表示目标抗原在炎症细胞中存在。
6. 异常强阳性(Aberrantly Strong Positive):表示目标抗原在组织或细胞中出现异常高的染色强度,超过了正常表达水平。
每种免疫组化实验都具有独特的结果判断标准,这些标准通常由经验丰富的病理学家或专业领域的专家制定和解读。
此外,合适的对照实验和质量控制也是确保免疫组化结果可靠性的重要因素。
总之,免疫组化结果判断标准对于准确解读免疫组化实验结果至关重要。
了解并遵循这些标准可以确保免疫组化实验结果的准确性和可靠性,从而对研究和临床诊断产生重要的参考价值。


免疫组化结果判读标准
免疫组化技术用于检测和定量特定蛋白质在组织或细胞中的表达情况。
免疫组化结果的判读标准会因所检测的蛋白质和研究目的的不同而有所不同。
以下是一般免疫组化结果判读的一般原则:
1. 强阳性(Strong positive):细胞或组织中存在大量的目标蛋白表达,通常显示为强烈的染色信号。
2. 中阳性(Moderate positive):细胞或组织中存在适度的目标蛋白表达,染色信号强度介于强阳性和弱阳性之间。
3. 弱阳性(Weak positive):细胞或组织中存在轻微的目标蛋白表达,染色信号强度较弱。
4. 阴性(Negative):细胞或组织中不存在目标蛋白的表达,通常显示为无或非特异性染色。
需要注意的是,免疫组化结果的判读可能还需要结合组织或细胞的生理背景、对照组样本以及其他实验数据进行综合分析。
与实验室或领域专家进行讨论和解释结果也是非常
重要的。
此外,具体研究领域和目的可能会有特定的判读标准,因此建议参考相关的研究文献和指南以确定适用的判读标准。

免疫组化实验结果的判定和分析免疫组化实验是一种广泛应用于生物医学研究领域的分析方法,它用于检测和定量分析细胞或组织中特定分子的表达水平。
该实验主要通过特异性抗体与目标分子结合并产生可视化信号来实现。
在进行免疫组化实验的结果判定和分析时,需要考虑多个因素,如抗体的选择、染色的强度和分布等。
首先,在实验结果的判定和分析时,抗体的选择是非常重要的因素之一、选择合适的抗体可以确保实验结果的准确性和可靠性。
抗体需要具有高度的特异性,能够与目标分子结合形成稳定的抗原-抗体复合物。
此外,抗体还需要具有良好的亲和力和灵敏度,以便能够捕获并检测到目标分子的最低表达水平。
其次,实验结果的判定和分析需要考虑染色的强度和分布。
免疫组化实验中常用的染色方法有荧光染色和酶标染色等。
染色的强度可以反映目标分子在细胞或组织中的表达水平,而染色的分布则可以提示目标分子的亚细胞定位或组织定位。
通过评估染色的强度和分布,可以对目标分子的表达及其在生物学过程中的作用进行初步分析。
另外,实验结果的判定和分析还需要结合负对照和阳性对照组的结果。
负对照组通常是将待测样本中的目标分子结合位点堵塞或与非特异性抗体结合,以排除非特异性染色的可能性。
而阳性对照组则是使用已知表达目标分子的样本进行染色,以验证实验方法的可靠性。
通过与负对照和阳性对照组的比较,可以进一步确定实验结果的准确性和特异性。
此外,实验结果的判定和分析还可以应用定量分析方法。
免疫组化实验通常使用染色强度的定量参数,如光密度或荧光信号强度来评估目标分子的表达水平。
这可以通过计算图像中目标区域的颜色强度来实现。
定量分析可以帮助研究者确定目标分子在不同条件下的变化趋势,并进一步研究其与疾病发生和发展的关联。
最后,实验结果的判定和分析应该结合其他相关的实验数据和研究背景进行综合分析。
免疫组化实验的结果往往只能提供目标分子在组织或细胞中的表达水平,而无法直接确定其功能和作用机制。
因此,需要将实验结果与其他实验手段和研究结果相结合,以获得更全面的分析结果。

免疫组化实验结果的判定和分析免疫组化实验结果的判定和分析就实验结果而言,免疫组化技术服务主要涉及抗体实验结果的描述与分析、图片的确定与选取、相关数据的提供,上述工作是免疫组化工作的重点内容。
只有严格的实验设计、标准的实验操作、专业化的结果分析才能满足客户的要求,更好地为客户提供最优质的服务。
免疫组化结果的判定原则:1•必须同时设对照染色。
没有对照染色的免疫组化染色结果是不可信的。
2•抗原表达必须在特定部位。
如LCA应定位在细胞膜上;CK应定位在细胞浆内;PCNA及p53 蛋白应定位在细胞核内;EMA 应定位在细胞膜上等等。
不在抗原所在部位的阳性着色,一概不能视为阳性。
3•阴性结果不能视为抗原不表达。
由于检测方法灵敏度有高低之分,有时可因染色方法灵敏度不够,而导致阴性反应,判断时应注意。
4•尽量避开出血、坏死及切片刀痕和界面边缘细胞的阳性表达,特别是酶免疫标记。
因为这类阳性着色多系内源干扰,或系人为因素所致。
5•对免疫组化标记结果的意义不能绝对化,应结合临床资料、X线等影像学及实验结果综合分析。
对照染色设计:(一)对照染色的目的设对照的目的是为了排除假阴性和假阳性。
假阴性的原因主要有三种:①组织处理不当,抗原丢失过多或被遮蔽;②抗体失活、效价过低或稀释度不合适(主要指一抗,即特异性抗体);③染色步骤遗漏及差错,或显色剂的选择、缓冲液pH 和离子强度不当等。
假阳性均系由多种因素造成的非特异着色所致,原因主要有:①自发荧光或内源酶等干扰;②抗体试剂不纯(特别是一抗);③操作失误,如污染、切片干枯或显色剂操作不当等;④Fc 受体的干扰,等等。
(二)对照的种类及其选用目的对照染色大致可分为四类:即阳性组织对照、阴性组织和阴性试剂对照及自身对照。
•阳性组织对照指用已证实含有靶抗原的同源及不同源组织切片或细胞涂片与待检实验切片同时作同样处理和免疫染色的组织对照。
正确的结果应呈现阳性,目的是为了证实所用免疫组化染色流程的有效性,排除假阴性的可能。
免疫组化结果判定标准免疫组化(Immunohistochemistry,IHC)是一种通过检测组织中特定蛋白的表达水平来帮助诊断疾病的技术。
在临床病理诊断中,免疫组化技术被广泛应用于肿瘤诊断、分子病理学研究以及预后评估等领域。
然而,正确解读免疫组化结果并不容易,因为需要根据特定的标准来判定阳性和阴性结果。
本文将介绍免疫组化结果的判定标准,以帮助临床医生和研究人员正确理解和解释免疫组化结果。
一、阳性结果的判定标准。
1. 强阳性(3+),细胞膜或细胞浆呈深褐色,且明显高于背景染色。
2. 中度阳性(2+),细胞膜或细胞浆呈较深的褐色,但略低于强阳性。
3. 弱阳性(1+),细胞膜或细胞浆呈浅褐色,仅略高于背景染色。
二、阴性结果的判定标准。
1. 弱阴性,细胞膜或细胞浆呈浅褐色,与背景染色无明显差异。
2. 中度阴性,细胞膜或细胞浆呈淡黄色,与背景染色相似。
3. 强阴性,细胞膜或细胞浆无染色。
三、结果的解读。
1. 阳性结果表明目标蛋白在组织中有表达,其强度与肿瘤的预后、治疗反应等密切相关。
2. 阴性结果可能表明目标蛋白在组织中无表达,但也有可能是技术操作或试剂质量等因素导致的假阴性结果,需结合临床和病理资料进行综合分析。
四、注意事项。
1. 免疫组化结果的判定应由经验丰富的专业人员进行,避免主观因素对结果的影响。
2. 在进行免疫组化实验时,应严格按照操作规程进行,确保实验的准确性和可靠性。
3. 结果的解读应结合临床和病理资料进行,避免片面解读导致诊断错误。
五、总结。
免疫组化结果的判定标准对于正确理解和解释免疫组化结果至关重要。
只有准确判定阳性和阴性结果,并结合临床和病理资料进行综合分析,才能更好地指导临床诊断和治疗。
因此,临床医生和研究人员在使用免疫组化技术时,应严格遵循标准操作规程,确保结果的准确性和可靠性,从而为临床诊断和治疗提供更可靠的依据。
免疫组化结果解读
免疫组化结果通常分为两种,一种是阴性,一种是阳性。
如果结果中kI67百分之80以上为阳性,那么就考虑有恶性肿瘤的发生。
免疫组化中的英文字母代表相应的组织器官的变化,通常来说,免疫组化需要和病例相结合,要看病历取材的位置,病理取材的器官组织。
免疫组化会根据阴性和阳性来准确的判断是否发生了恶性肿瘤。
如果存在恶性肿瘤的情况一定要结合患者的临床症状,实验室检查,影像学检查进行综合判断,制定良好的治疗方案。